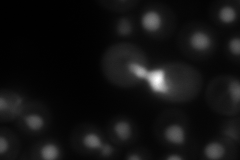
YNL246W
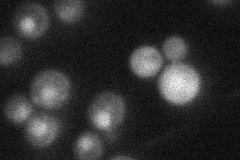
YNL246W

View description
NAP family histone chaperone; binds to histones and Rtt109p, stimulating histone acetyltransferase activity; possesses nucleosome assembly activity in vitro; proposed role in vacuolar protein sorting and in double-strand break repair
Localization:
Intensity:
Fold change:
Significance:
-
C’ GFP library in SD

nucleus33.15 -
N' NOP1pr-GFP in SD

nucleus123.961 -
N' TEF2pr-mCherry in SD
nucleus208.692 -
N' NATIVEpr-GFP in SD
punctate,nucleus28.049 -
N' TEF2pr-VC and Cyto-VN in SD

#N/A0 -
C’ GFP library in SD+DTT

nucleus29.590.89No -
C’ GFP library in SD+H2O2

nucleus31.310.94No -
C’ GFP library in Starvation Media

nucleus30.940.93No -
C’ GFP library on the background of Pup2-DaMP

nucleus -
C’ GFP library on the background of CCT mutant

nucleus34.78521.04887No
